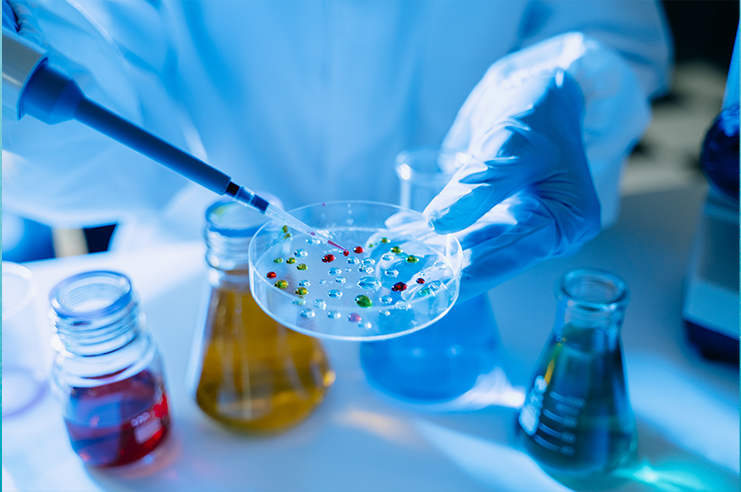
sterile bags, sterile injectables, sterile water for injection

At US Specialty Formulations (USSF), we understand the complexities and challenges of drug discovery and development. Our commitment is to transform innovative ideas into market-ready solutions that improve patient outcomes. With a dedicated team of experts and a fully integrated approach, we offer comprehensive drug discovery and development services, supporting our partners at every stage of the journey.
Drug discovery and development is a multifaceted process that requires a deep understanding of biology, chemistry, and pharmacology. It involves identifying potential drug candidates, optimizing them for efficacy, safety, stability and guiding them through rigorous testing and regulatory approval processes. At US Specialty Formulations, our
drug formulation development and fill / finish services are meticulously designed to seamlessly integrate these steps, ensuring a smooth transition from concept to reality.